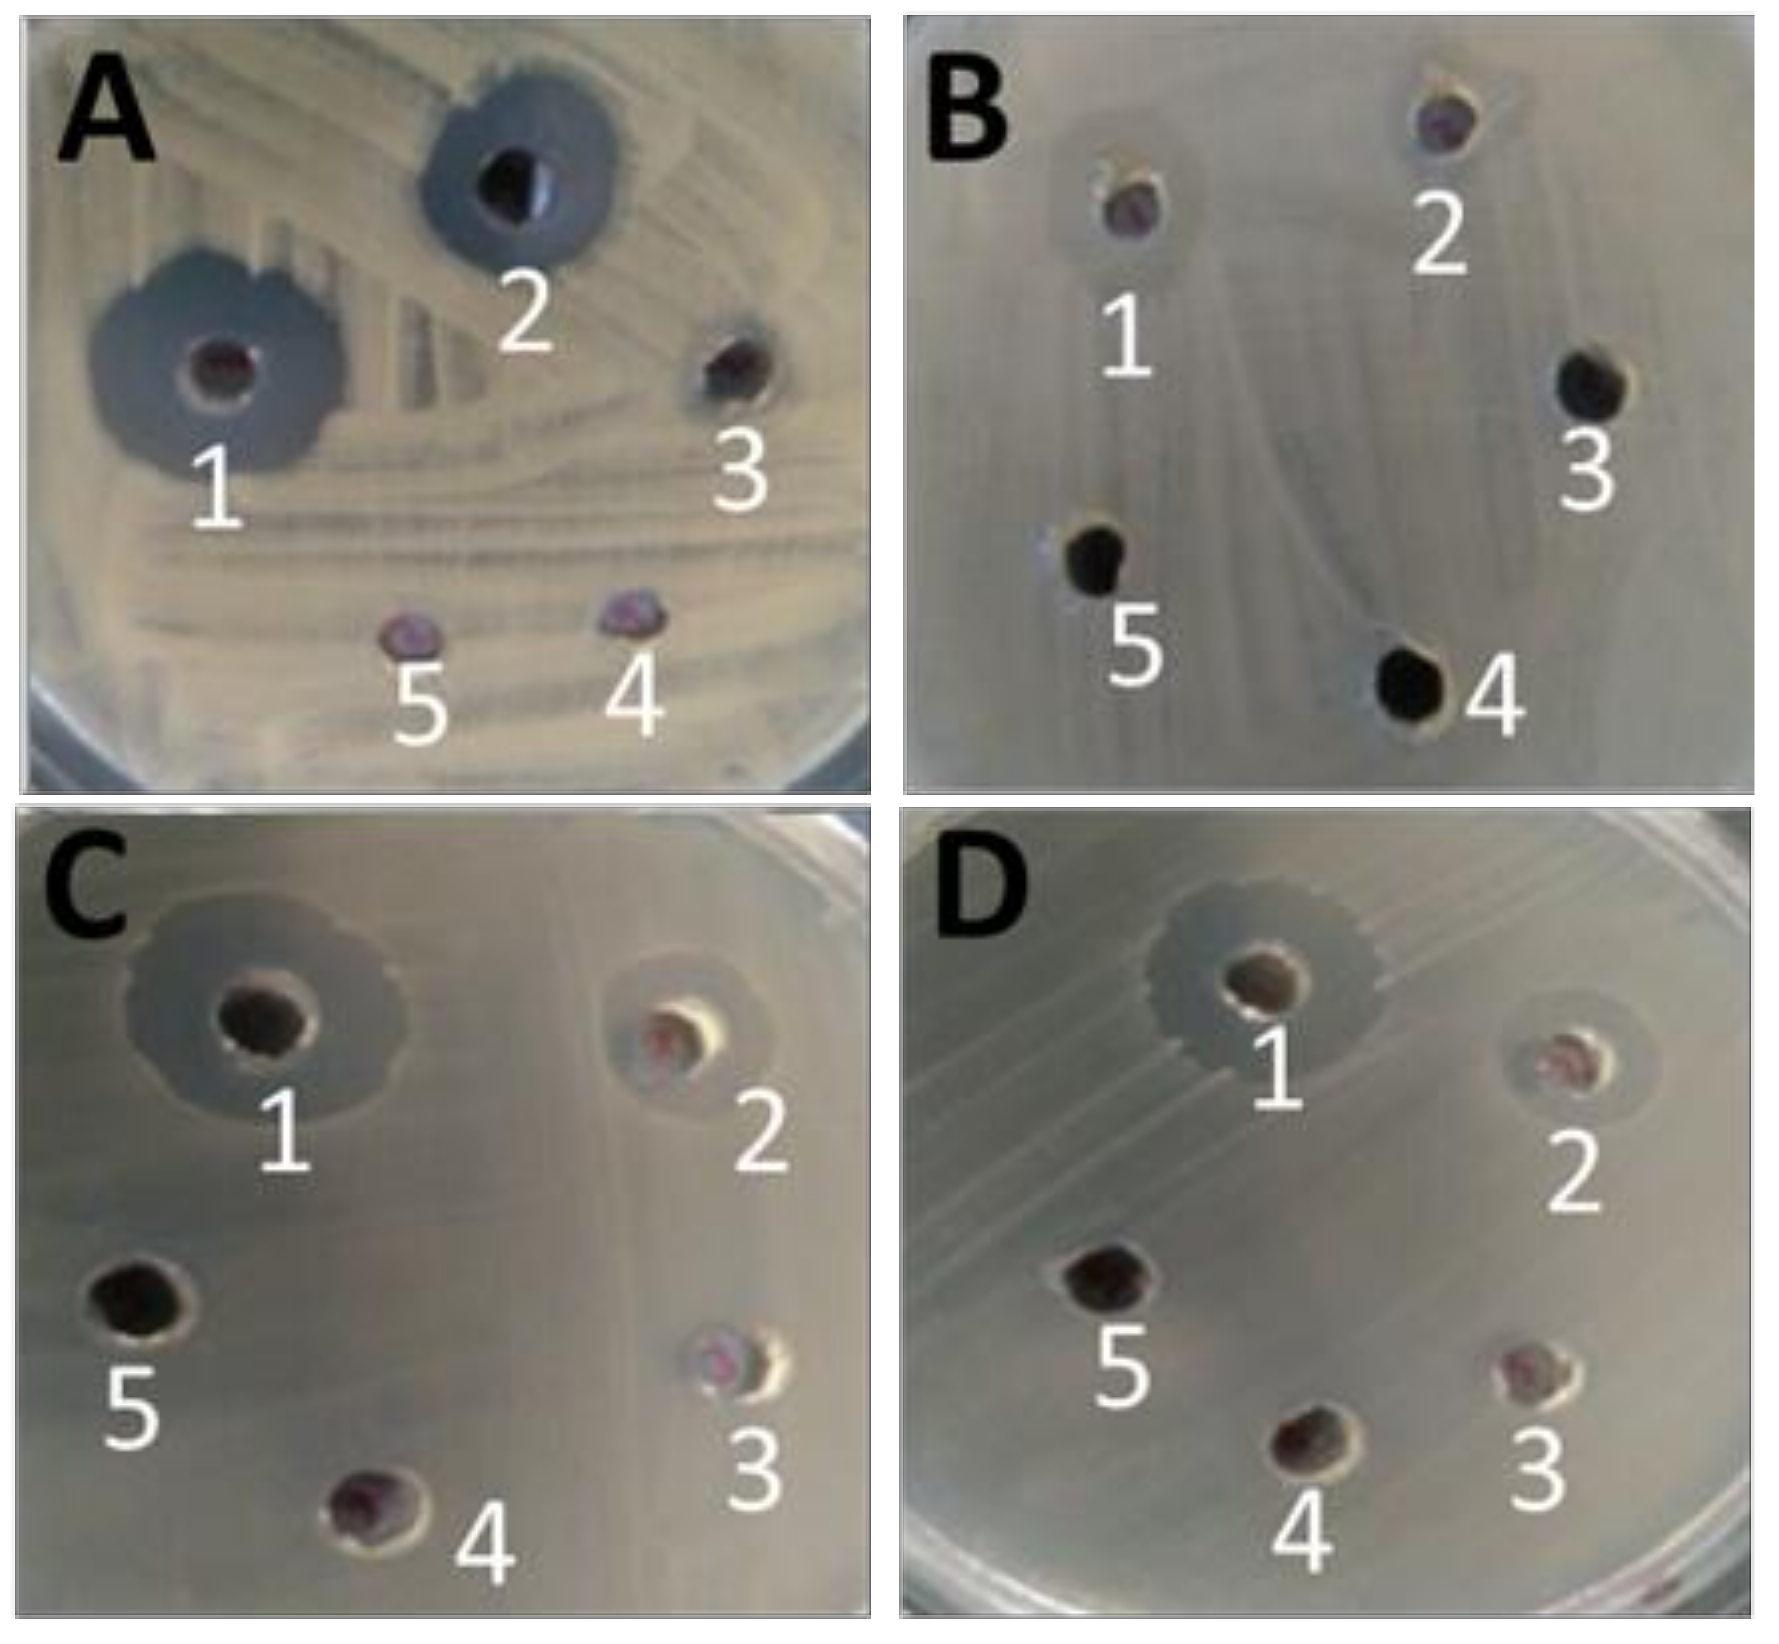
Ijms 23 02833 g004 550

Garvicin KS, a Broad-Spectrum Bacteriocin Protects Zebrafish Larvae against Lactococcus garvieae Infection
Abstract
:1. Importance
2. Introduction
3. Materials and Methods
3.1. Source of Antimicrobial Peptide Garvicin KS
3.2. GarKS Inhibition of Fish and Foodborne Bacterial Pathogens
3.3. Cytotoxicity Test of GarKS in Fish Cell Lines Based on LDH Test
3.4. Infection Study of Zebrafish Larvae against Lactococcus garvieae
3.5. Statistical Analyses
4. Results
4.1. Inhibition of Fish Pathogens by GarKS
4.2. Inhibition of Foodborne Pathogens by GarKS
4.3. Inhibition of Bacterial Fish Pathogens at Different GarKS Concentrations
4.4. Cytotoxicity of GarKS on CHSE-214 and RTG-2 Cells
4.5. Kaplan Meyer’s Survival Analysis of Zebrafish Larvae Challenged with L. garvieae
5. Discussion
Author Contributions
Funding
Institutional Review Board Statement
Informed Consent Statement
Data Availability Statement
Conflicts of Interest
References
- FAO. The State of World Fisheries and Aquaculture, Opportunities and Challenges; Food and Agriculture Organization of the United Nations: Rome, Italy, 2012. [Google Scholar]
- Munang’andu, H.M. Intracellular Bacterial Infections: A Challenge for Developing Cellular Mediated Immunity Vaccines for Farmed Fish. Microorganisms 2018, 6, 33. [Google Scholar] [CrossRef] [PubMed] [Green Version]
- O’Connor, P.M.; Kuniyoshi, T.M.; Oliveira, R.P.; Hill, C.; Ross, R.P.; Cotter, P.D. Antimicrobials for food and feed; a bacteriocin perspective. Curr. Opin. Biotechnol. 2020, 61, 160–167. [Google Scholar] [CrossRef] [PubMed]
- Karpinski, T.; Szkaradkiewicz, A.; Caballero, B.; Finglas, P.; Toldrá, F. Encyclopedia of Food and Health; Elsevier: Amsterdam, The Netherlands, 2016; p. 1. [Google Scholar]
- Cotter, P.; Hill, C.; Ross, R. Bacteriocins: Developing innate immunity for food. Nat. Rev. Genet. 2005, 3, 777–788. [Google Scholar] [CrossRef] [PubMed]
- Heilbronner, S.; Krismer, B.; Brötz-Oesterhelt, H.; Peschel, A. The microbiome-shaping roles of bacteriocins. Nat. Rev. Genet. 2021, 19, 726–739. [Google Scholar] [CrossRef]
- Hammami, R.; Zouhir, A.; Le Lay, C.; Ben Hamida, J.; Fliss, I. BACTIBASE second release: A database and tool platform for bacteriocin characterization. BMC Microbiol. 2010, 10, 22. [Google Scholar] [CrossRef] [Green Version]
- AL Kassaa, I.; Rafei, R.; Moukhtar, M.; Zaylaa, M.; Gharsallaoui, A.; Asehraou, A.; El Omari, K.; Shahin, A.; Hamze, M.; Chihib, N.-E. LABiocin database: A new database designed specifically for Lactic Acid Bacteria bacteriocins. Int. J. Antimicrob. Agents 2019, 54, 771–779. [Google Scholar] [CrossRef]
- Carraturo, A.; Raieta, K.; Ottaviani, D.; Russo, G.L. Inhibition of Vibrio parahaemolyticus by a bacteriocin-like inhibitory substance (BLIS) produced by Vibrio mediterranei 1. J. Appl. Microbiol. 2006, 101, 234–241. [Google Scholar] [CrossRef]
- Bhugaloo-Vial, P.; Dousset, X.; Metivier, A.; Sorokine, O.; Anglade, P.; Boyaval, P.; Marion, D. Purification and amino acid sequences of piscicocins V1a and V1b, two class IIa bacteriocins secreted by Carnobacterium piscicola V1 that display significantly different levels of specific inhibitory activity. Appl. Environ. Microbiol. 1996, 62, 4410–4416. [Google Scholar] [CrossRef] [Green Version]
- Ovchinnikov, K.V.; Chi, H.; Mehmeti, I.; Holo, H.; Nes, I.F.; Diep, D.B. Novel Group of Leaderless Multipeptide Bacteriocins from Gram-Positive Bacteria. Appl. Environ. Microbiol. 2016, 82, 5216–5224. [Google Scholar] [CrossRef] [Green Version]
- Kranjec, C.; Kristensen, S.S.; Bartkiewicz, K.T.; Brønner, M.; Cavanagh, J.P.; Srikantam, A.; Mathiesen, G.; Diep, D.B. A bacteriocin-based treatment option for Staphylococcus haemolyticus biofilms. Sci. Rep. 2021, 11, 13909. [Google Scholar] [CrossRef]
- Kranjec, C.; Ovchinnikov, K.V.; Grønseth, T.; Ebineshan, K.; Srikantam, A.; Diep, D.B. A bacteriocin-based antimicrobial formulation to effectively disrupt the cell viability of methicillin-resistant Staphylococcus aureus (MRSA) biofilms. Npj Biofilms Microbiomes 2020, 6, 1–13. [Google Scholar] [CrossRef] [PubMed]
- Meyburgh, C.M.; Bragg, R.R.; Boucher, C.E. Lactococcus garvieae: An emerging bacterial pathogen of fish. Dis. Aquat. Org. 2017, 123, 67–79. [Google Scholar] [CrossRef] [PubMed]
- Vendrell, D.; Balcázar, J.L.; Ruiz-Zarzuela, I.; de Blas, I.; Gironés, O.; Múzquiz, J.L. Lactococcus garvieae in fish: A review. Comp. Immunol. Microbiol. Infect. Dis. 2006, 29, 177–198. [Google Scholar] [CrossRef] [PubMed]
- Choksi, T.T.; Dadani, F. Reviewing the Emergence ofLactococcus garvieae: A Case of Catheter Associated Urinary Tract Infection Caused by Lactococcus garvieaeand Escherichia coli Coinfection. Case Rep. Infect. Dis. 2017, 2017, 1–4. [Google Scholar] [CrossRef] [Green Version]
- Gibello, A.; Galán-Sánchez, F.; Blanco, M.D.M.; Rodríguez-Iglesias, M.; Domínguez, L.; Fernandez-Garayzabal, J.F. The zoonotic potential of Lactococcus garvieae: An overview on microbiology, epidemiology, virulence factors and relationship with its presence in foods. Res. Veter-Sci. 2016, 109, 59–70. [Google Scholar] [CrossRef]
- Shahi, N.; Mallik, S.; Sahoo, M.; Chandra, S.; Singh, A. First report on characterization and pathogenicity study of emerging Lactococcus garvieae infection in farmed rainbow trout, Oncorhynchus mykiss (Walbaum), from India. Transbound. Emerg. Dis. 2018, 65, 1039–1048. [Google Scholar] [CrossRef]
- Aguado-Urda, M.; Rodríguez-Bertos, A.; Heras, A.I.D.L.; Blanco, M.M.; Acosta, F.; Cid, R.; Fernández-Garayzábal, J.F.; Gibello, A. Experimental Lactococcus garvieae infection in zebrafish and first evidence of its ability to invade non-phagocytic cells. Veter-Microbiol. 2014, 171, 248–254. [Google Scholar] [CrossRef]
- Hai, C.I.M.; Ovchinnikov, K.; Holo, H.; Ingolf, F.N.; Dzung, B. Antimicrobial Peptide Produced by Lactococcus garvieae with a Broad Inhibition Spectrum World Academy of Science. Eng. Technol. Int. J. Agric. Biosyst. Eng. 2017, 4, 3. [Google Scholar]
- Sobanska, M.; Scholz, S.; Nyman, A.-M.; Cesnaitis, R.; Alonso, S.G.; Klüver, N.; Kühne, R.; Tyle, H.; De Knecht, J.; Dang, Z.; et al. Applicability of the fish embryo acute toxicity (FET) test (OECD 236) in the regulatory context of Registration, Evaluation, Authorisation, and Restriction of Chemicals (REACH). Environ. Toxicol. Chem. 2017, 37, 657–670. [Google Scholar] [CrossRef]
- Chi, H.; Holo, H. Synergistic Antimicrobial Activity Between the Broad Spectrum Bacteriocin Garvicin KS and Nisin, Farnesol and Polymyxin B Against Gram-Positive and Gram-Negative Bacteria. Curr. Microbiol. 2018, 75, 272–277. [Google Scholar] [CrossRef] [Green Version]
- Cieslewicz, M.J.; Chaffin, D.; Glusman, G.; Kasper, D.; Madan, A.; Rodrigues, S.; Fahey, J.; Wessels, M.R.; Rubens, C.E. Structural and Genetic Diversity of Group B Streptococcus Capsular Polysaccharides. Infect. Immun. 2005, 73, 3096–3103. [Google Scholar] [CrossRef] [Green Version]
- Minnaganti, V.R.; Patel, P.J.; Iancu, D.; Schoch, P.E.; Cunha, B.A. Necrotizing fasciitis caused by Aeromonas hydrophila. Heart Lung 2000, 29, 306–308. [Google Scholar] [CrossRef]
- FAO. Risk Profile—Group B Streptococcus (GBS)—Streptococcus Agalactiae Sequence Type (ST) 283 in Freshwater Fish; Food and Agriculture Organization of the United Nations Bangkok: Bangkok, Thailand, 2021. [Google Scholar]
- Al-Bayati, A.; Douedi, S.; Alsaoudi, G.; Mosseri, M.; Albustani, S.; Upadhyaya, V.; Gornish, N.; Elsawaf, M. Meningitis from invasive Streptococcus agalactiae in a healthy young adult. IDCases 2020, 21, e00907. [Google Scholar] [CrossRef] [PubMed]
- Borrero, J.; Brede, D.A.; Skaugen, M.; Diep, D.B.; Herranz, C.; Nes, I.F.; Cintas, L.M.; Hernández, P.E. Characterization of Garvicin ML, a Novel Circular Bacteriocin Produced by Lactococcus garvieae DCC43, Isolated from Mallard Ducks (Anas platyrhynchos). Appl. Environ. Microbiol. 2011, 77, 369–373. [Google Scholar] [CrossRef] [PubMed] [Green Version]
- Maldonado-Barragan, A.; Cardenas, N.; Martïnez, B.; Ruiz-Barba, J.L.; Fernandez-Garayzabal, J.F.; Rodriguez, J.M.; Gibello, A.; Garvicin, A. A novel class IId bacteriocin from Lactococcus garvieae that inhibits septum formation in L. garvieae strains. Appl. Environ. Microbiol. 2013, 79, 4336–4346. [Google Scholar] [CrossRef] [PubMed] [Green Version]
- Tosukhowong, A.; Zendo, T.; Visessanguan, W.; Roytrakul, S.; Pumpuang, L.; Jaresitthikunchai, J.; Sonomoto, K. Garvieacin Q, a Novel Class II Bacteriocin from Lactococcus garvieae BCC 43578. Appl. Environ. Microbiol. 2012, 78, 1619–1623. [Google Scholar] [CrossRef] [Green Version]
- Villani, F.; Aponte, M.; Blaiotta, G.; Mauriello, G.; Pepe, O.; Moschetti, G. Detection and characterization of a bacteriocin, garviecin L1-5, produced by Lactococcus garvieae isolated from raw cow’s milk. J. Appl. Microbiol. 2001, 90, 430–439. [Google Scholar] [CrossRef]
- Dicks, L.M.; Dreyer, L.; Smith, C.; Van Staden, A.D. A review: The fate of bacteriocins in the human gastro-intestinal tract: Do they cross the gut–blood barrier? Front. Microbiol. 2018, 9, 2297. [Google Scholar] [CrossRef]
- Maher, S.; McClean, S. Investigation of the cytotoxicity of eukaryotic and prokaryotic antimicrobial peptides in intestinal epithelial cells in vitro. Biochem. Pharmacol. 2006, 71, 1289–1298. [Google Scholar] [CrossRef]
- Jasniewski, J.; Cailliez-Grimal, C.; Chevalot, I.; Millière, J.-B.; Revol-Junelles, A.-M. Interactions between two carnobacteriocins Cbn BM1 and Cbn B2 from Carnobacterium maltaromaticum CP5 on target bacteria and Caco-2 cells. Food Chem. Toxicol. 2009, 47, 893–897. [Google Scholar] [CrossRef]
- Varsha, K.K.; Nampoothiri, K.M.; Shilpa, G.; Priya, S. Antimicrobial activity and cytotoxicity trait of a bioactive peptide purified from Lactococcus garvieae subsp. bovis BSN307 T. Lett. Appl. Microbiol. 2021, 72, 706–713. [Google Scholar] [CrossRef]
- Hetz, C.; Bono, M.R.; Barros, L.F.; Lagos, R. Microcin E492, a channel-forming bacteriocin from Klebsiella pneumoniae, induces apoptosis in some human cell lines. Proc. Natl. Acad. Sci. USA 2002, 99, 2696–2701. [Google Scholar] [CrossRef] [Green Version]
- Cox, C.R.; Coburn, P.S.; Gilmore, M.S. Enterococcal Cytolysin: A Novel Two Component Peptide System that Serves as a Bacterial Defense Against Eukaryotic and Prokaryotic Cells. Curr. Protein Pept. Sci. 2005, 6, 77–84. [Google Scholar] [CrossRef] [PubMed]
- Ravindran, C.; Varatharajan, G.; Rajasabapathy, R.; Sreepada, R. Antibacterial Activity of Marine Bacillus Substances against Vibrio cholerae and Staphylococcus aureus and In Vivo Evaluation Using Embryonic Zebrafish Test System. Indian J. Pharm. Sci. 2016, 78, 417–422. [Google Scholar] [CrossRef]
- Kalyanasundaram, R.; Radhakrishnan, M.; Anbarasu, S. Activity and Toxicity Assessment of Partially Purified Bacteriocin from Lactic Acid Bacteria against Mycobacterium Kansasii. Ann. Rom. Soc. Cell Biol. 2021, 1, 6715–6721. [Google Scholar]
- Tseng, C.-C.; Murni, L.; Han, T.-W.; Arfiati, D.; Shih, H.-T.; Hu, S.-Y. Molecular Characterization and Heterologous Production of the Bacteriocin Peocin, a DNA Starvation/Stationary Phase Protection Protein, from Paenibacillus ehimensis NPUST1. Molecules 2019, 24, 2516. [Google Scholar] [CrossRef] [Green Version]
- Abriouel, H.; Franz, C.M.; Omar, N.B.; Gálvez, A. Diversity and applications of Bacillus bacteriocins. FEMS Microbiol. Rev. 2011, 35, 201–232. [Google Scholar] [CrossRef] [Green Version]
- Davis, E.E.; Frangakis, S.; Katsanis, N. Interpreting human genetic variation with in vivo zebrafish assays. Biochim. Biophys. Acta (BBA)-Mol. Basis Dis. 2014, 1842, 1960–1970. [Google Scholar] [CrossRef] [Green Version]
- Phillips, J.B.; Westerfield, M. Zebrafish models in translational research: Tipping the scales toward advancements in human health. Dis. Model. Mech. 2014, 7, 739–743. [Google Scholar] [CrossRef] [Green Version]
- Patton, E.E.; Tobin, D.M. Spotlight on zebrafish: The next wave of translational research. Dis. Model. Mech. 2019, 12, dmm039370. [Google Scholar] [CrossRef] [Green Version]
- Postlethwait, J.H.; Woods, I.G.; Ngo-Hazelett, P.; Yan, Y.-L.; Kelly, P.D.; Chu, F.; Huang, H.; Hill-Force, A.; Talbot, W.S. Zebrafish Comparative Genomics and the Origins of Vertebrate Chromosomes. Genome Res. 2000, 10, 1890–1902. [Google Scholar] [CrossRef] [PubMed] [Green Version]

| List of Bacteria | Strain/ Serotype | Source of Isolate | Inhibition Zone Diameter (mm) | Growth Temp (°C) | Susceptibility to GarKS | |||
|---|---|---|---|---|---|---|---|---|
| Plate-1 | Plate-2 | Plate-3 | Mean | |||||
| Lactococcus garvieae | b. baraja | Trout | 19 | 18.5 | 19 | 18.83 | 30 | Yes |
| Lactococcus garvieae | lg | Trout | 18 | 18 | 18 | 18.00 | 30 | Yes |
| Lactococcus garvieae | perbembe | Trout | 18 | 19 | 18.5 | 18.50 | 30 | Yes |
| Lactococcus garvieae | cp-1 | Trout | 19 | 18.5 | 19 | 18.83 | 30 | Yes |
| Lactococcus garvieae | BA063090 | Eel | 18 | 18.5 | 18 | 18.17 | 30 | Yes |
| Lactococcus garvieae | KS1546 | From cow milk | 0 | 0 | 0 | 0.00 | 30 | No |
| Streptococcus agalactiae | bio I | Tilapia | 16.5 | 16 | 17 | 16.50 | 37 | Yes |
| Streptococcus agalactiae | bio II | Tilapia | 17.8 | 17 | 17.5 | 17.43 | 37 | Yes |
| Aeromonas salmonicida | 6421 | Atlantic salmon | 19 | 19.5 | 19 | 19.17 | 25 | Yes |
| Aeromonas salmonicida | 6422 | Atlantic salmon | 8.5 | 8.3 | 8.5 | 8.43 | 25 | Yes (partial) |
| Aeromonas hydrophila | 19 | Labeo rohita | 9.5 | 9.0 | 9.3 | 9.40 | 37 | Yes (slight) |
| Edwardsiella tarda | FC05 | Olive flounder | 0 | 0 | 0 | 0 | 37 | No |
| Yersinia ruckeri | NVS | Atlantic salmon | 0 | 0 | 0 | 0 | 25 | No |
| Klebsiella pneumoniae | 13883 | ATCC | 0 | 0 | 0 | 0 | 37 | No |
| Escherichia coli | 25922 | ATCC | 0 | 0 | 0 | 0 | 37 | No |
| Salmonella enterica | 4931 | ATCC | 0 | 0 | 0 | 0 | 37 | No |
| Microorganism | Incubation Temperature on Mueller–Hinton Agar | GarKS Concentration and Inhibition Zone Diameter in mm | ||||
|---|---|---|---|---|---|---|
| 33 µg/mL | 3.3 µg/mL | 0.33 µg/mL | 0.033 µg/mL | 0.0033 µg/mL | ||
| Aeromonas salmonicida strain 6421 | 25 °C | 19.0 | 10.0 | 0 | 0 | 0 |
| Aeromonas hydrophila strain 19 | 37 °C | 14.5 | 6.7 | 0 | 0 | 0 |
| Streptococcus agalactiae serotype Ia | 37 °C | 18.5 | 9 | 0 | 0 | 0 |
| Streptococcus agalactiae serotype Ib | 37 °C | 18.0 | 8.7 | 0 | 0 | 0 |
Publisher’s Note: MDPI stays neutral with regard to jurisdictional claims in published maps and institutional affiliations. |
© 2022 by the authors. Licensee MDPI, Basel, Switzerland. This article is an open access article distributed under the terms and conditions of the Creative Commons Attribution (CC BY) license (https://creativecommons.org/licenses/by/4.0/).
Share and Cite
Dubey, S.; Diep, D.B.; Evensen, Ø.; Munang’andu, H.M. Garvicin KS, a Broad-Spectrum Bacteriocin Protects Zebrafish Larvae against Lactococcus garvieae Infection. Int. J. Mol. Sci. 2022, 23, 2833. https://doi.org/10.3390/ijms23052833
Dubey S, Diep DB, Evensen Ø, Munang’andu HM. Garvicin KS, a Broad-Spectrum Bacteriocin Protects Zebrafish Larvae against Lactococcus garvieae Infection. International Journal of Molecular Sciences. 2022; 23(5):2833. https://doi.org/10.3390/ijms23052833
Chicago/Turabian StyleDubey, Saurabh, Dzung B. Diep, Øystein Evensen, and Hetron M. Munang’andu. 2022. "Garvicin KS, a Broad-Spectrum Bacteriocin Protects Zebrafish Larvae against Lactococcus garvieae Infection" International Journal of Molecular Sciences 23, no. 5: 2833. https://doi.org/10.3390/ijms23052833
APA StyleDubey, S., Diep, D. B., Evensen, Ø., & Munang’andu, H. M. (2022). Garvicin KS, a Broad-Spectrum Bacteriocin Protects Zebrafish Larvae against Lactococcus garvieae Infection. International Journal of Molecular Sciences, 23(5), 2833. https://doi.org/10.3390/ijms23052833

